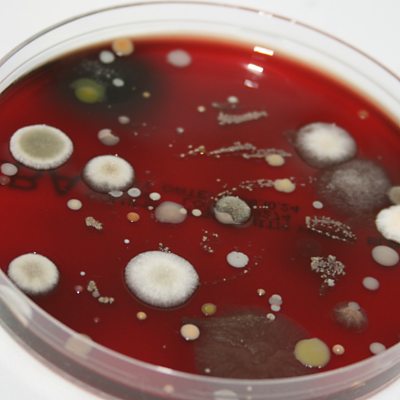

Episode details

Available for over a year
Christoph Tang and Steve Jones discuss the power of penicillin and antibiotics
Programme WebsiteUse ГЫСїґ«ГЅ.com or the new ГЫСїґ«ГЅ App to listen to ГЫСїґ«ГЅ podcasts, Radio 4 and the World Service outside the UK.
Available for over a year
Christoph Tang and Steve Jones discuss the power of penicillin and antibiotics
Programme Website